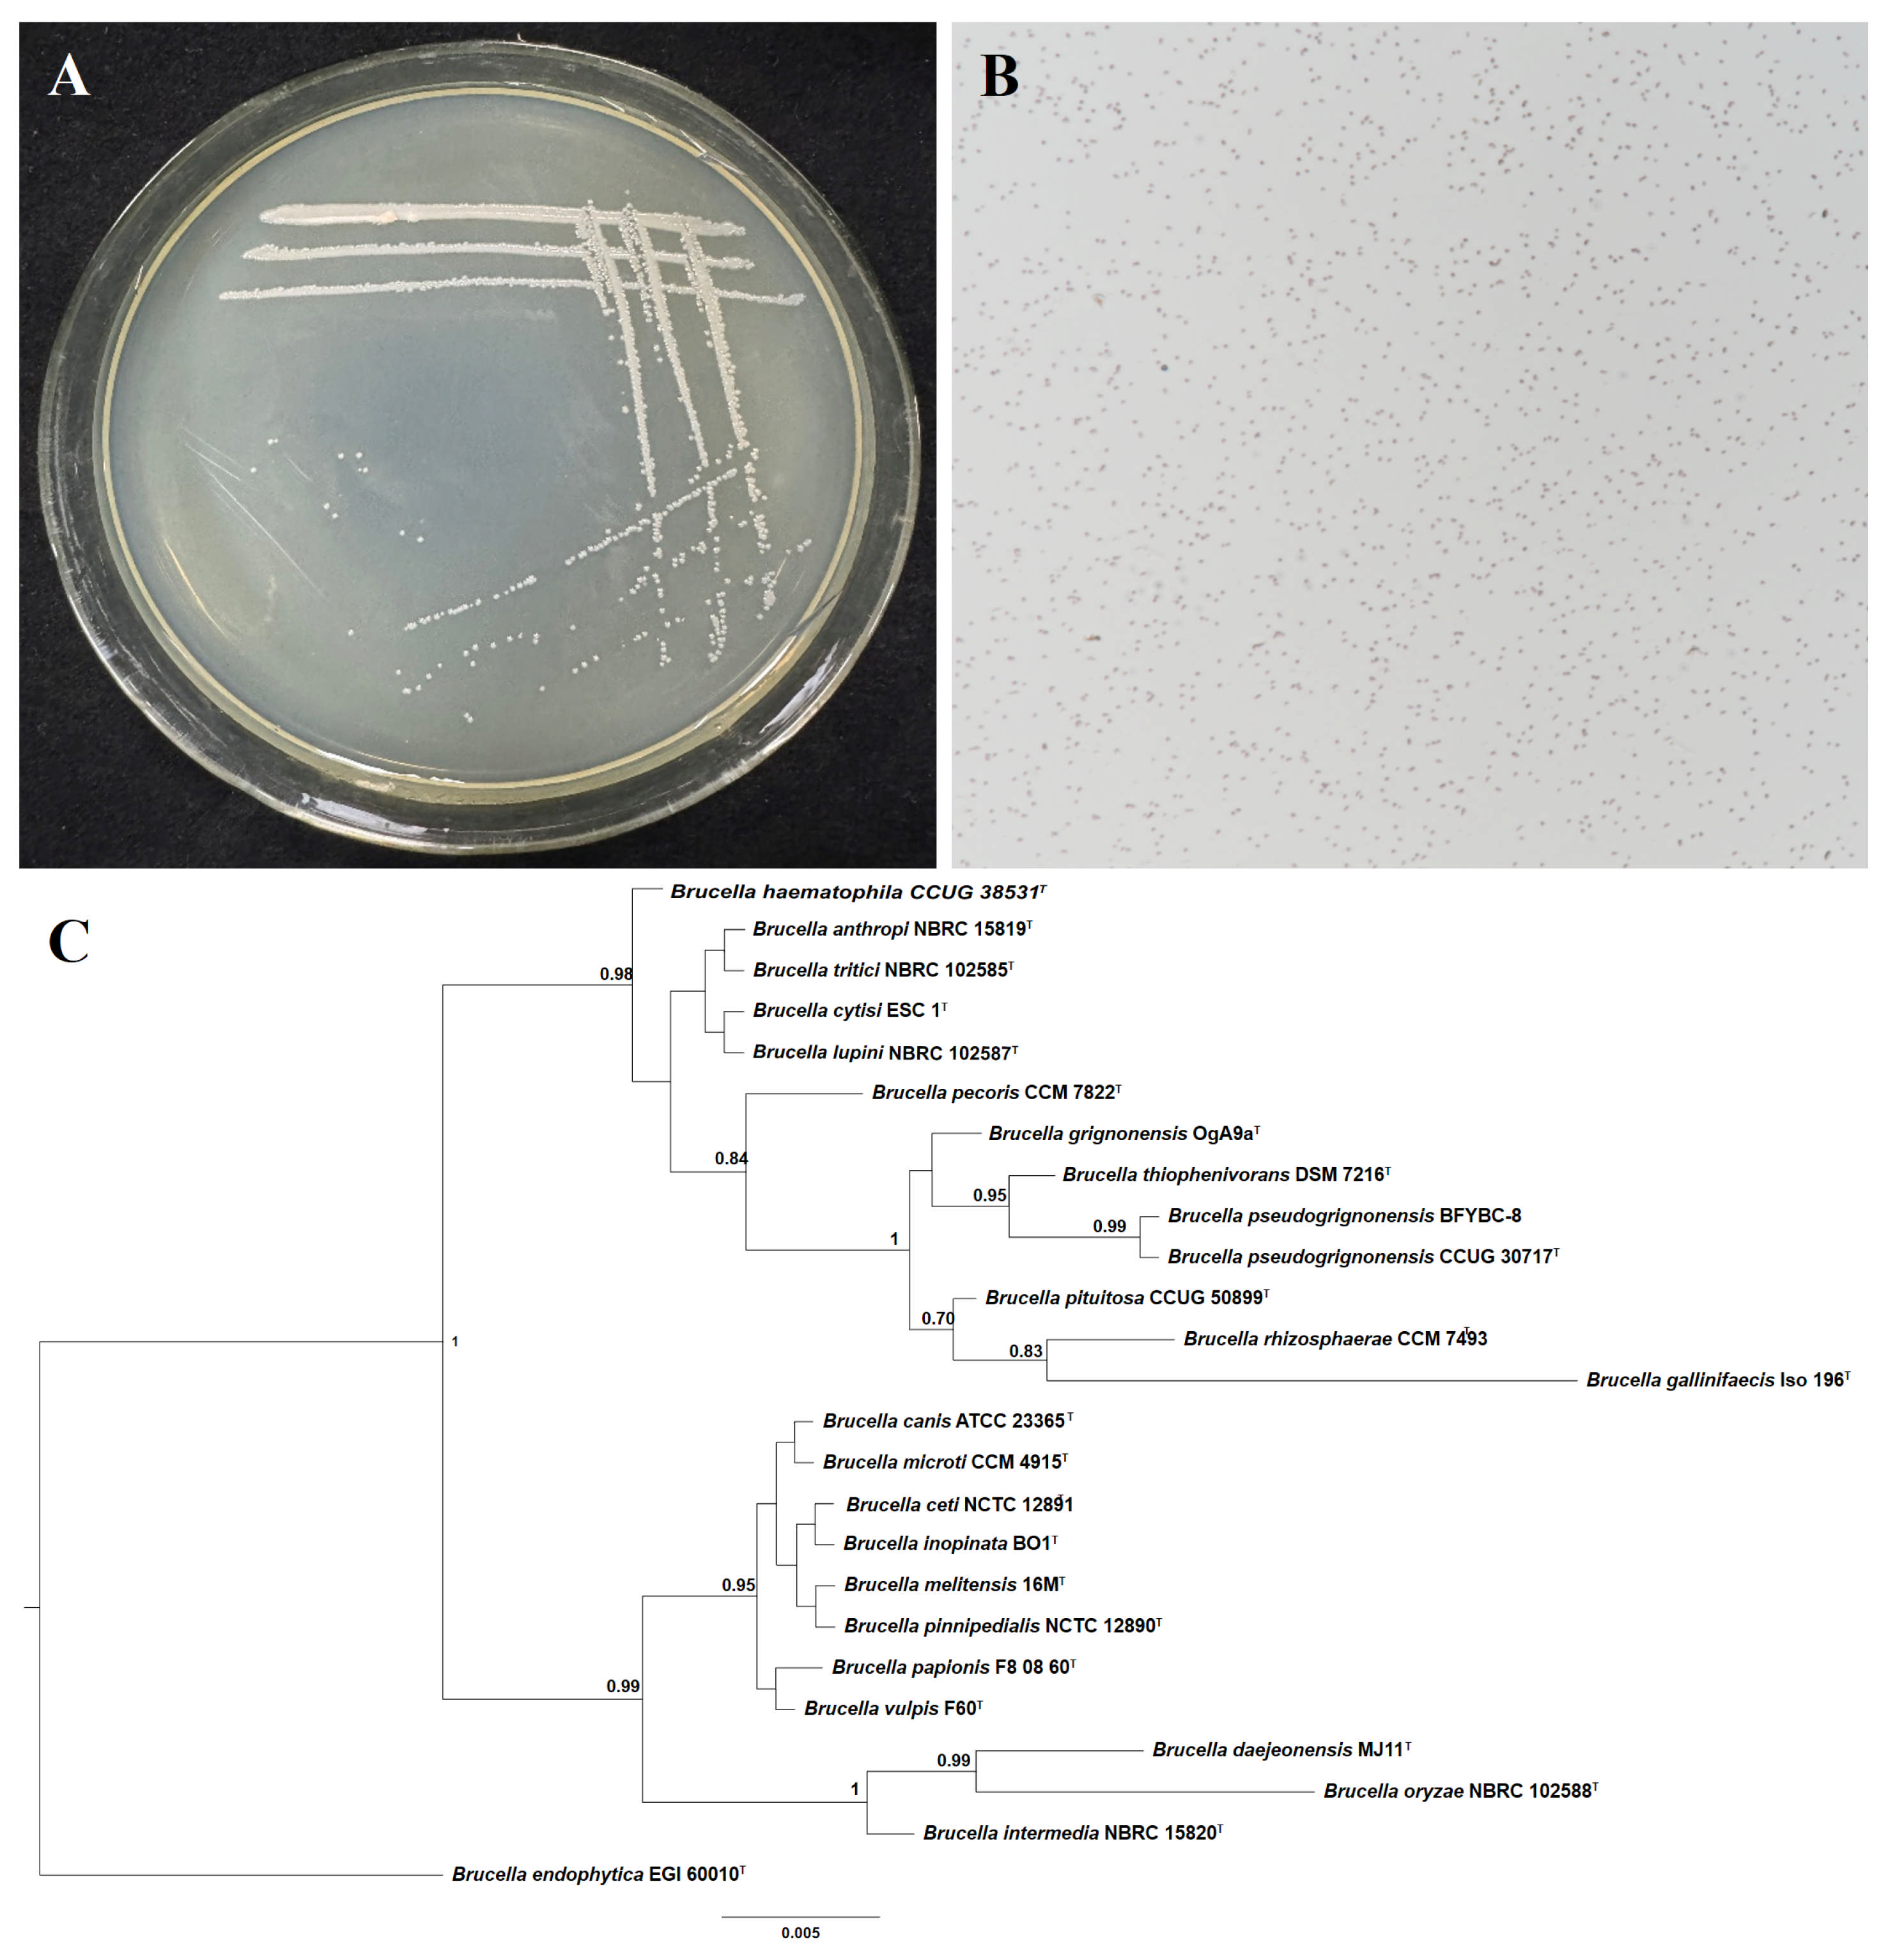

Herbicidal Control Potential of the Endophytic Bacterium B. pseudorignonensis BFYBC-8 Isolated from E. crus-galli Seeds
Abstract
1. Introduction
2. Materials and Methods
2.1. Plant Material
2.2. Isolation and Screening of Pathogenic Bacteria from E. crus-galli Seeds
2.3. Strain Identification
2.4. Pot Experiment of Pathogenic Strains
2.5. GFP Labeling and Colonization Test of Pathogenic Strains BFYBC-8
2.6. Crop Safety Test of Strain BFYBC-8
2.7. The Inhibitory Activity and Thermal Stability of Secondary Metabolites of Strain BFYBC-8
2.8. Component Identification of Strain BFYBC-8 Extract by Liquid Chromatography-Mass Spectrometry (LC-MS)
2.9. Experimental Apparatus
2.10. Data Analysis
3. Results
3.1. Isolation and Screening of Pathogenic Strains
3.2. Identification of Strain BFYBC-8
3.3. Pot Experiment of Pathogenic Strains B. pseudorignonensis BFYBC-8
3.4. Colonization of B. pseudorignonensisBFYBC-8
3.5. Inhibitory Activity of Secondary Metabolites of B. pseudorignonensis BFYBC-8
3.6. Crop Safety Test of B. pseudorignonensis BFYBC-8
3.7. LC-MS Identification of Bioherbicidal Metabolites in B. pseudorignonensis BFYBC-8 Crude Extract
4. Discussion
5. Conclusions
Author Contributions
Funding
Institutional Review Board Statement
Informed Consent Statement
Data Availability Statement
Conflicts of Interest
References
- Zhang, H.; Mu, D.; Li, Y.; Li, X.; Yan, X.; Li, K.; Jiao, Y.; Li, J.; Lin, H.; Lin, W.; et al. Glutathione S-transferase activity facilitates rice tolerance to the b arnyard grass root exudate DIMBOA. BMC Plant Biol. 2024, 24, 117. [Google Scholar]
- Rahaman, F.; Juraimi, A.S.; Rafii, M.Y.; Uddin, M.K.; Hassan, L.; Chowdhury, A.K.; Bashar, H.M.K. Allelopathic effect of selected rice (Oryza sativa) varieties against barnyard grass (Echinochloa crus-gulli). Plants 2021, 10, 2017. [Google Scholar] [CrossRef] [PubMed]
- Lübke Bonow, J.F.; Andres, A.; Pinto Lamego, F. var. mitis metabolism as resistance mechanism to imazapyr and imazapic. Acta Agronómica 2020, 69, 117–123. [Google Scholar] [CrossRef]
- Lu, Y.; Silveira, M.L.; Vendramini, J.M.B.; Erickson, J.E.; Li, Y. Biosolids and biochar application effects on bahiagrass herbage accumu lation and nutritive value. Agron. J. 2020, 112, 1330–1345. [Google Scholar] [CrossRef]
- Bajsa-Hirschel, J.; Pan, Z.; Duke, S.O. Rice momilactone gene cluster: Transcriptional response to barnyard grass (Echinochloa crus-galli). Mol. Biol. Rep. 2020, 47, 1507–1512. [Google Scholar] [CrossRef]
- Radhakrishnan, R.; Alqarawi, A.A.; Abd_Allah, E.F. Bioherbicides: Current knowledge on weed control mechanism. Ecotoxicol. Environ. Saf. 2018, 158, 131–138. [Google Scholar] [CrossRef]
- Treiber, L.; Pezolt, C.; Zeng, H.; Schrey, H.; Jungwirth, S.; Shekhar, A.; Stadler, M.; Bilitewski, U.; Erb-Brinkmann, M.; Schobert, R. Dual agents: Fungal macrocidins and synthetic analogues with herbicida l and antibiofilm activities. Antibiotics 2021, 10, 1022. [Google Scholar] [CrossRef]
- Cimmino, A.; Masi, M.; Evidente, M.; Superchi, S.; Evidente, A. Fungal phytotoxins with potential herbicidal activity: Chemical and bi ological characterization. Nat. Prod. Rep. 2015, 32, 1629–1653. [Google Scholar] [CrossRef]
- Li, W.; Shen, S.; Chen, H. Bio-herbicidal potential of wheat rhizosphere bacteria on Avena fatua L. grass. Bioengineered 2021, 12, 516–526. [Google Scholar] [CrossRef]
- Gealy, D.R.; Rohila, J.S.; Boykin, D.L. Genetic potential of rice under alternate-wetting-and-drying irrigation management for barnyard grass (Echinochloa crus-galli) suppres sion and grain yield production. Weed Sci. 2019, 67, 453–462. [Google Scholar] [CrossRef]
- Charudattan, R. Ecological, practical, and political inputs into selection of weed tar gets: What makes a good biological control target? Biol. Control 2005, 35, 183–196. [Google Scholar] [CrossRef]
- Avelino, A.C.D.; De Faria, D.A.; Pallaoro, D.S.; Arieira, G.O.d.; Neto, A.B.; Abreu, J.G.d.; Camili, E.C.; Kobayasti, L.; Cabral, C.E.A. Effect of fertilizer on palisadegrass seeds pathogens. J. Exp. Agric. Int. 2019, 34, 1–11. [Google Scholar] [CrossRef]
- Tekiela, D.R. Effect of the Bioherbicide Pseudomonas fluorescens D7 on downy brome (Bromus tectorum). Rangel. Ecol. Manag. 2020, 73, 753–755. [Google Scholar] [CrossRef]
- Boyette, C.D.; Hoagland, R.E. Bioherbicidal potential of Xanthomonas campestris for controlling Conyza canadensis. Biocontrol Sci. Technol. 2015, 25, 229–237. [Google Scholar] [CrossRef]
- Kalyana Babu, B.; Sood, S.; Kumar, D.; Joshi, A.; Pattanayak, A.; Kant, L.; Upadhyaya, H.D. Cross-genera transferability of rice and finger millet genomic SSRs to barnyard millet (Echinochloa spp.). 3 Biotech 2018, 8, 95. [Google Scholar] [CrossRef]
- Shen, S.; Xu, G.; Clements, D.R.; Jin, G.; Zhang, F.; Tao, D.; Xu, P. Competitive and allelopathic effects of wild rice accessions (Oryza longistaminata) at different growth stages. Pak. J. Biol. Sci. 2016, 19, 82–88. [Google Scholar] [CrossRef]
- Sharma, S.; Saxena, D.C.; Riar, C.S. Analysing the effect of germination on phenolics, dietary fibres, mine rals and γ-amino butyric acid contents of barnyard millet (Echinochloa frumentaceae). Food Biosci. 2016, 13, 60–68. [Google Scholar] [CrossRef]
- da Silva, K.A.; Ferreira, N.G.C.; de Oliveira, C.M.R. Hotspots of soil pollution: Possible risks of glyphosate and aminometh ylphosphonic acid on terrestrial ecosystems and human health. Environ Int. 2023, 179, 108135. [Google Scholar] [CrossRef]
- Mohd Ghazi, R.; Nik Yusoff, N.R.; Abdul Halim, N.S.; Wahab, I.R.A.; Ab Latif, N.; Hasmoni, S.H.; Ahmad Zaini, M.A.; Zakaria, Z.A. Health effects of herbicides and its current removal strategies. Bioengineered 2023, 14, 2259526. [Google Scholar] [CrossRef]
- Singh, M.K.; Singh, N.K.; Singh, S.P. Impact of Herbicide Use on Soil Microorganisms and Their Diversity. In Plant Responses to Soil Pollution; Singh, P., Prasad, S.M., Eds.; Springer: Singapore, 2020; pp. 179–194. [Google Scholar]
- Nazni, P.; Devi, R.S. Effect of processing on the characteristics changes in barnyard and foxtail millet. J. Food Process. Amp Technol. 2016, 7, 566. [Google Scholar]
- Sanavy, S.A.M.M.; Delfieh, M.; Ghahary, S. Evaluation of allelopathic effects of iranian rice cultivars (Oryza sativa L.) on growth factors of barnyard grass (Echinochloa crus-galli L.). J. Agric. Sci. 2015, 7, 129. [Google Scholar]
- Katoh, K.; Toh, H. Parallelization of the MAFFT multiple sequence alignment program. Bioinformatics 2010, 26, 1899–1900. [Google Scholar] [CrossRef]
- Kumar, S.; Stecher, G.; Tamura, K. MEGA7: Molecular evolutionary genetics analysis version 7.0 for bigger datasets. Mol. Biol. Evol. 2016, 33, 1870–1874. [Google Scholar] [CrossRef]
- Huelsenbeck, J.P.; Ronquist, F. MRBAYES: Bayesian inference of phylogenetic trees. Bioinformatics 2001, 17, 754–755. [Google Scholar] [CrossRef] [PubMed]
- Liang, P.Y.; Jiang, J.W.; Sun, Z.X.; Li, Y.Y.; Yang, C.L.; Zhou, Y. Klebsiella michiganensis: A nitrogen-fixing endohyphal bacterium from Ustilago maydis. AMB Express 2023, 13, 146. [Google Scholar] [CrossRef] [PubMed]
- Wang, P.; Zhang, X.; Kong, C. The response of allelopathic rice growth and microbial feedback to barnyard grass infestation in a paddy field experiment. Eur. J. Soil Biol. 2013, 56, 26–32. [Google Scholar] [CrossRef]
- Roop, R.M.; Barton, I.S.; Hopersberger, D.; Martin, D.W. Uncovering the hidden credentials of Brucella virulence. Microbiol. Mol. Biol. Rev. 2021, 85, 10–1128. [Google Scholar] [CrossRef]
- Suárez-Esquivel, M.; Chaves-Olarte, E.; Moreno, E.; Guzmán-Verri, C. Brucella genomics: Macro and micro evolution. Int. J. Mol. Sci. 2020, 21, 7749. [Google Scholar] [CrossRef]
- Ahn, J.K.; Hahn, S.J.; Kim, J.T.; Khanh, T.D.; Chung, I.M. Evaluation of allelopathic potential among rice (Oryza sativa L.) germ plasm for control of Echinochloa crus-galli P. Beauv in the field. Crop Prot. 2004, 24, 413–419. [Google Scholar] [CrossRef]
- Caldwell, C.J.; Hynes, R.K.; Boyetchko, S.M.; Korber, D.R. Colonization and bioherbicidal activity on green foxtail by Pseudomonas fluorescens BRG100 in a pesta formulation. Can. J. Microbiol. 2012, 58, 1–9. [Google Scholar] [CrossRef]
- Malik, R.J.; Dixon, M.H.; Bever, J.D. Mycorrhizal composition can predict foliar pathogen colonization in soybean. Biol. Control 2016, 103, 46–53. [Google Scholar] [CrossRef]
- Johnson, D.R.; Wyse, D.L.; Keith, J.J. Controlling weeds with phytopathogenic bacteria. Weed Technol. 1996, 10, 621–624. [Google Scholar] [CrossRef]
- Tan, M.; Zhang, Y.; Zhang, Y.; Vurro, M.; Qiang, S. Effects of Bipolaris yamadae strain HXDC-1-2 as a bioherbicide against Echinochloa crus-gall in rice and dry fields. Pest Manag. Sci. 2024, 80, 3786–3794. [Google Scholar] [CrossRef]
- Deng, H.; Xu, Q.; Guo, H.-Y.; Huang, X.; Chen, F.; Jin, L.; Quan, Z.-S.; Shen, Q.-K. Application of cinnamic acid in the structural modification of natural products: A review. Phytochemistry 2022, 206, 113532. [Google Scholar] [CrossRef]
- Cai, Z.M.; Peng, J.Q.; Chen, Y.; Tao, L.; Zhang, Y.Y.; Fu, L.Y.; Long, Q.D.; Shen, X.C. 1,8-Cineole: A review of source, biological activities, and application. J. Asian Nat. Prod. Res. 2020, 23, 938–954. [Google Scholar] [CrossRef] [PubMed]
- Quinn, J.; Kessell, A.; Weston, L. Secondary Plant Products Causing Photosensitization in Grazing Herbivo res: Their Structure, Activity and Regulation. Int. J. Mol. Sci. 2014, 15, 1441–1465. [Google Scholar] [CrossRef] [PubMed]
- Pernak, J.; Niemczak, M.; Chrzanowski, Ł.; Ławniczak, Ł.; Fochtman, P.; Marcinkowska, K.; Praczyk, T. Betaine and carnitine derivatives as herbicidal ionic liquids. Chem. A Eur. J. 2016, 22, 12012–12021. [Google Scholar] [CrossRef] [PubMed]

| Instrument Name | Model | Manufacturer/Source |
|---|---|---|
| Cryostat Microtome | CM1860UV | Leica Microsystems, Wetzlar, Germany |
| High-Pressure Steam Sterilizer (Autoclave) | GR60DA | ZEALWAY Instrument Co., Ltd., Xiamen, China |
| UV-Vis Spectrophotometer | UV-5100B | Yuanxi Instrument Co., Ltd., Shanghai China |
| Confocal Microscope | DMi8 | Leica Microsystems, Wetzlar, Germany |
| Biological Microscope | BH200 | Sunway Optical Technology Group Co., Ltd., Sichuan, China |
| pH Meter | FE28 Standard | Mettler-Toledo Instrument Co., Ltd., Shanghai, China |
| Pipette (Adjustable Volume Pipettor) | Research® Plus | Eppendorf AG, Hamburg, Germany |
| Illuminated Incubator Shaker | HZ250LG | Ruihua Instrument Equipment Co., Ltd., Wuhan, China |
| Laboratory Water Purification System | RO D1800-E | Heqi Instrument Co., Ltd., Shanghai, China |
| Intelligent Illuminated Plant Growth Chamber | SPX-150-GB | Langgan Laboratory Equipment Co., Ltd., Shanghai, China |
| Laminar Flow Clean Bench (Double-sided) | SW-CJ-2FD | Antai Air Technology Co., Ltd., Suzhou, China |
| Electric Thermostatic Blow-drying Oven | DHG-9246A | Jinghong Experimental Equipment Co., Ltd., Shanghai, China |
| Ultrasonic Cleaner | KQ2200 | Shumei Ultrasonic Instrument Co., Ltd., Kunshan, China |
| Digital Caliper | 150T | DR. JOHANNES HEIDENHAIN Co., Ltd., Beijing, China |
| Refrigerated Centrifuge | 5430R | Eppendorf AG, Hamburg, Germany |
| Flake Ice Maker | SIM-F140AY65-PC | Lingchu Environmental Protection Instrument Co., Ltd., Shanghai, China |
| Thermal Cycler (PCR Machine) | Mastercycler nexus | Eppendorf AG, Hamburg, Germany |
| Vortex Mixer | G560E | Scientific Industries, Inc., New York, NY, USA |
| Digital Camera | EOS R6 Mark II (EF100mm f/2.8L Macro IS USM) | Canon Co., Ltd., Beijing, China |
| Magnetic Stirrer | IT-09A5 | Yiheng Scientific Instrument Co., Ltd., Shanghai, China |
| Electric Thermostatic Water Bath | DK-98-II | Tester Instrument Co., Ltd., Tianjin, China |
| Electrophoresis System | DYY-4C | Liuyi Instrument Factor, Beijing, China |
| Refrigerator (Non-frost) | BCD-218WLDPPU1 | Haier Smart Home Co., Ltd., Qingdao, China |
| Ultra-Low Temperature Freezer | DW-86L828J | Haier Special Electrical Appliance Co., Ltd., Qingdao, China |
| Mini Centrifuge | D1008E | Jinggong Industrial Co., Ltd., Shanghai, China |
| Gel Documentation System | Gel Doc XR+ | Bio-Rad Laboratories, Inc., California, CA, USA |
| Electronic Balance | LQ-C6002 | Feiya Weighing Apparatus Co., Ltd., Shenzhen, China |
| Precision Electronic Balance | FA1204B | Jingke Tianmei Scientific Instrument Co., Ltd., Shanghai, China |
| High-Throughput Tissue Homogenizer | XU-YM-48 | Xiniu Lab Instrument Co., Ltd., Shanghai, China |
| Induction Cooker | HK-22 | Zhenyu Electric Appliance Co., Ltd., Zhongshan China |
| Treatment | Inhibition Rate of Plant Height (%) | Inhibition Rate of Root Elongation (%) |
|---|---|---|
| BFYBC-1 | −2.9 ± 2.3 kl | −10.4 ± 13.3 cde |
| BFYBC-2 | 7.9 ± 5.0 fghij | 6.5 ± 4.8 bc |
| BFYBC-3 | −3.4 ± 4.1 kl | 0.3 ± 9.4 bcd |
| BFYBC-4 | 12.4 ± 2.7 def | 4.7 ± 3.9 bcd |
| BFYBC-5 | 9.0 ± 2.3 fhgij | 4.8 ± 7.3 bcd |
| BFYBC-6 | 9.9 ± 2.4 fghi | 4.0 ± 6.3 bcd |
| BFYBC-7 | 2.2 ± 1.0 jk | 8.6 ± 6.4 b |
| BFYBC-8 | 25.1 ± 1.8 ab | 86.3 ± 2.0 a |
| BFYBC-9 | 10.3 ± 7.9 fgh | −2.1 ± 5.9 bcd |
| BFYBC-10 | 11.8 ± 1.9 efg | −0.5 ± 8.2 bcd |
| BFYBC-11 | 25.7 ± 2.5 a | 11.3 ± 4.5 b |
| BFYBC-12 | 30.3 ± 1.7 a | 0.0 ± 11.1 bcd |
| BFYBC-13 | 14.0 ± 2.9 def | −0.2 ± 4.3 bcd |
| BFYBC-14 | 18.8 ± 2.5 bcd | 10.3 ± 8.5 b |
| BFYBC-15 | 3.4 ± 1.4 ijk | −2.8 ± 6.9 bcde |
| BFYBC-16 | 4.6 ± 4.8 hij | 2.4 ± 4.4 bcd |
| BFYBC-17 | 24.4 ± 2.1 abc | −2.1 ± 6.9 bcd |
| BFYBC-18 | 17.7 ± 4.7 cde | 4.2 ± 17.0 bcd |
| BFYBC-19 | −4.8 ± 2.1 l | −19.2 ± 6.9 e |
| BFYBC-20 | 9.1 ± 2.7 fghi | −1.6 ± 9.5 bcd |
| BFYBC-21 | 5.3 ± 2.6 ghij | −9.4 ± 8.7 cde |
| BFYBC-22 | 7.7 ± 3.1 fghij | −10.8 ± 10.3 de |
| BFYBC-23 | 8.3 ± 2.1 fghij | 3.4 ± 6.0 bcd |
| BFYBC-24 | 8.8 ± 4.6 fghij | 5.4 ± 5.7 bcd |
| BFYBC-25 | 12.1 ± 3.2 defg | −2.4 ± 7.2 bcde |
| BFYBC-26 | 7.3 ± 3.7 fghij | −2.0 ± 10.8 bcd |
| BFYBC-27 | 9.1 ± 3.5 fghi | 1.9 ± 2.2 bcd |
| BFYBC-28 | 4.3 ± 2.6 hij | −4.7 ± 11.9 bcde |
| Treatment | Inhibition Rate of Plant Height (%) | Inhibition Rate of Root Elongation (%) |
|---|---|---|
| BFYBC-8 | 16.7 ± 1.8 a | 85.1 ± 3.7 a |
| BFYBC-11 | 1.7 ± 3.3 b | 2.3 ± 6.6 b |
| BFYBC-12 | −1.4 ± 4.7 b | 1.9 ± 6.3 b |
| BFYBC-17 | 2.8 ± 3.2 b | 5.2 ± 6.4 b |
| Temperature | Inhibition Rate of Plant Height (%) | Inhibition Rate of Root Elongation (%) |
|---|---|---|
| 28 °C | 17.0 ± 2.4 | 83.0 ± 1.3 |
| 60 °C | 17.1 ± 0.4 | 83.8 ± 1.6 |
| 80 °C | 20.8 ± 2.9 | 84.1 ± 2.5 |
| 100 °C | 18.5 ± 1.4 | 85.2 ± 0.7 |
| Material Type | Molecular Formula | Ion Binding Form | Mass/Charge | Retention Time |
|---|---|---|---|---|
| Benzoylaconine | C24H29NO5 | [M + H]+ | 590.2509 | 1.27 |
| N-glycyl-L-leucine | C8H16N2O3 | [M + H]+ | 189.0862 | 1.36 |
| Allyloxy Polyethylene Glycol-15 | C4H5O-(C2H4O)15-C4H5O·NH4 | [M + Na]+ | 832.3412 | 1.99 |
| Allyloxy Ammonium Salt | ||||
| Betaine | C5H11NO2 | [M + H]+ | 118.0642 | 2.18 |
| 8-Quinolinol | C9H7NO | [M + H]+ | 146.059 | 2.18 |
| N-TAmP-FHxSAP | C15H21F13NO5S | [M + H]+ | 571.2601 | 2.62 |
| Avermectin B1a | C48H72O14 | [M + H]+ | 895.3938 | 3.95 |
| Poly(tetrahydrofuran) diol-1,2-ammonium salt | C48H96O12·NH4 | [M + H]+ | 883.5565 | 6.78 |
| Ivermectin | C48H74O14 | [M + H]+ | 897.5727 | 6.79 |
| 1-Methyl-2-pyrrolidone | C5H9NO | [M + H]+ | 100.1111 | 8.95 |
| Cinnamic Acid | C9H8O2 | [M + H]+ | 149.0227 | 9.04 |
| Prothioconazole Desthiometabolite | C14H15F3N2O2S | [M + H]+ | 312.3251 | 11.76 |
| 5:3 Fluorotelomer Betaine | C12H16F9NO3S | [M + H]+ | 414.2678 | 12.08 |
| trans-Anethole | C10H12O | [M + H]+ | 149.0229 | 20.95 |
| p-Phenylenediaminealdehyde | C9H11NO | [M + H]+ | 150.0255 | 21.58 |
| Vinpocetine | C21H26N2O3 | [M + H]+ | 355.0682 | 25.74 |
Disclaimer/Publisher’s Note: The statements, opinions and data contained in all publications are solely those of the individual author(s) and contributor(s) and not of MDPI and/or the editor(s). MDPI and/or the editor(s) disclaim responsibility for any injury to people or property resulting from any ideas, methods, instructions or products referred to in the content. |
© 2025 by the authors. Licensee MDPI, Basel, Switzerland. This article is an open access article distributed under the terms and conditions of the Creative Commons Attribution (CC BY) license (https://creativecommons.org/licenses/by/4.0/).
Share and Cite
Yang, D.; He, Q.; Wang, Q.; Zhou, J.; Ke, H.; Wen, X.; Pan, J.; Zhou, Y.; Jiang, J. Herbicidal Control Potential of the Endophytic Bacterium B. pseudorignonensis BFYBC-8 Isolated from E. crus-galli Seeds. Microorganisms 2025, 13, 2293. https://doi.org/10.3390/microorganisms13102293
Yang D, He Q, Wang Q, Zhou J, Ke H, Wen X, Pan J, Zhou Y, Jiang J. Herbicidal Control Potential of the Endophytic Bacterium B. pseudorignonensis BFYBC-8 Isolated from E. crus-galli Seeds. Microorganisms. 2025; 13(10):2293. https://doi.org/10.3390/microorganisms13102293
Chicago/Turabian StyleYang, Dashan, Quanlong He, Qingling Wang, Jing Zhou, Haiyan Ke, Xin Wen, Jiawei Pan, Yi Zhou, and Jianwei Jiang. 2025. "Herbicidal Control Potential of the Endophytic Bacterium B. pseudorignonensis BFYBC-8 Isolated from E. crus-galli Seeds" Microorganisms 13, no. 10: 2293. https://doi.org/10.3390/microorganisms13102293
APA StyleYang, D., He, Q., Wang, Q., Zhou, J., Ke, H., Wen, X., Pan, J., Zhou, Y., & Jiang, J. (2025). Herbicidal Control Potential of the Endophytic Bacterium B. pseudorignonensis BFYBC-8 Isolated from E. crus-galli Seeds. Microorganisms, 13(10), 2293. https://doi.org/10.3390/microorganisms13102293
